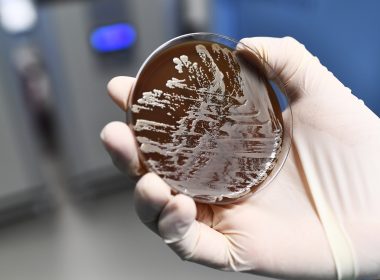

by Jenny VAUGHAN Agence France Presse HANOI, Vietnam (AFP) — Millions of pigs have been culled as African Swine Fever cuts through China and beyond, devastating global food chains, with pork prices expected to soar from the food markets of Hong Kong to American dinner tables. Outbreaks have been reported in Vietnam, Mongolia, Cambodia, Hong Kong and China — the world’s biggest pork producer and consumer. Experts warn it could take years to contain […]
Health
New drug therapy slows spread of pancreatic cancer: study
by Issam AHMED For people diagnosed with advanced pancreatic cancer, the outlook is about as grim as it gets: the average patient won’t live longer than a year. But a new study involving a targeted drug therapy has demonstrated it may be possible to significantly slow its spread, with a third of patients receiving the medication still alive two years into a clinical trial, a researcher reported on Sunday. The trial specifically looked at patients […]
World’s tiniest surviving baby born in California
by Jocelyne ZABLIT LOS ANGELES, United States (AFP) — A California hospital on Wednesday disclosed the birth of the world’s smallest baby ever to survive, weighing a mere 245 grams (8.6 ounces) — the same as a large apple — when she was born. The girl, nicknamed Saybie by hospital staff, was born 23 weeks and three days into her mother’s pregnancy at Sharp Mary Birch Hospital for Women and Newborns in San Diego. The […]
‘Burn-out’ is an ‘occupational phenomenon’ not disease: WHO
GENEVA, Switzerland (AFP) — The World Health Organization said Tuesday that “burn-out” remains an “occupational phenomenon” that could lead someone to seek care but it is not considered a medical condition. The clarification came a day after the WHO mistakenly said it had listed burn-out in its International Classification of Diseases (ICD) for the first time. The World Health Assembly, WHO’s main annual meeting which wraps up on Tuesday, approved at the weekend the […]
Singapore reports first case of rare monkeypox virus
SINGAPORE, Singapore (AFP) — Singapore has reported its first ever case of monkeypox, brought in by a Nigerian man thought to have contracted the rare virus by eating bushmeat at a wedding. Symptoms in humans of monkeypox — which is endemic in parts of Central and Western Africa — include lesions, fever, muscle ache and chills. Transmission is usually via close contact with infected animals such as rodents and monkeys and is limited between people. […]
DR Congo: Ebola claims over 1,000 lives, Guterres commits ‘whole’ UN system, to help ‘end the outbreak’
Now in its tenth month, the Ebola epidemic in the Democratic Republic of the Congo (DRC) has claimed more than a thousand lives, prompting Secretary-General António Guterres to throw the support of “the whole United Nations system” into stemming the spread of the deadly virus. Mr. Guterres expressed concern over the number of new Ebola cases in the east of the DRC on Wednesday, reiterating UN support “for efforts to end the outbreak”. “With important […]
Scientists develop device to detect bacteria in minutes, not days
WASHINGTON, United States (AFP) – The era of doctors prescribing patients powerful antibiotics while they wait for lab reports could soon be numbered, with a new device returning results within minutes instead of days. It was invented by a team at Penn State University and described in a paper published in the Proceedings of the National Academy of Sciences on Monday. Co-developed by Pak Kin Wong, a professor of biomedical engineering and mechanical engineering, the […]
Two die from measles in Switzerland as cases rise
GENEVA, Switzerland (AFP) — Switzerland has registered two deaths from measles this year, health authorities said Thursday, stressing the importance of vaccinating against the highly contagious disease. The health ministry warned that the number of measles cases was on the rise this year, with 155 people infected, including two who had died. A man in his thirties, who had never been vaccinated against the disease, died after being infected by a family member, it said. […]
Like Uber, but for organs: first kidney delivered by drone
WASHINGTON, United States (AFP) — A kidney needed for transplantation has been delivered by a drone for the first time ever, the University of Maryland Medical Center said, a development that could herald faster and safer organ transport. The specially designed high-tech drone was fitted with equipment to monitor the kidney along its three-mile (five kilometers) journey to its recipient: a 44-year-old woman from Baltimore who had spent eight years on dialysis before the procedure. […]
Encouraging a healthier lifestyle: OGAWA brand launched in SM City Fairview
MANILA, Philippines – OGAWA, a committed brand in encouraging a healthier lifestyle in the Philippines recently opened its another outlet at the SM City Fairview. The ribbon cutting was attended by Ms. Marianne Rodillo, Marketing Communications Manager of OGAWA Philippines, Mr. Marvin Dionson, the Person In Charge of OGAWA SM Fairview together with Sales Advisors, Mr. Mervin Piano, Mr. Jonard Laguidao, and Ms. Felaine Jacildo. Present also were Ms. Arbie Cadalin, Assistant Mall Manager of […]
Under-fives’ daily screen time should be kept to 60 minutes only, warns WHO
Toddlers should spend no more than 60 minutes passively watching a screen every day, while babies under 12 months should have none, to ensure that they grow up fit and well, the World Health Organization (WHO) said on Wednesday, as part of a campaign to tackle the global obesity crisis. In recommendations specifically aimed at under-fives for the first time, the UN health agency said that some than 40 million children around the globe – […]
US records 695 measles cases, most since 2000
NEW YORK, United States (AFP) –The United States recorded 695 cases of measles in 2019, the most of any year since the disease was declared eliminated in 2000, health authorities said Wednesday. “The high number of cases in 2019 is primarily the result of a few large outbreaks — one in Washington State and two large outbreaks in New York that started in late 2018,” the Centers for Disease Control and Prevention said in a […]